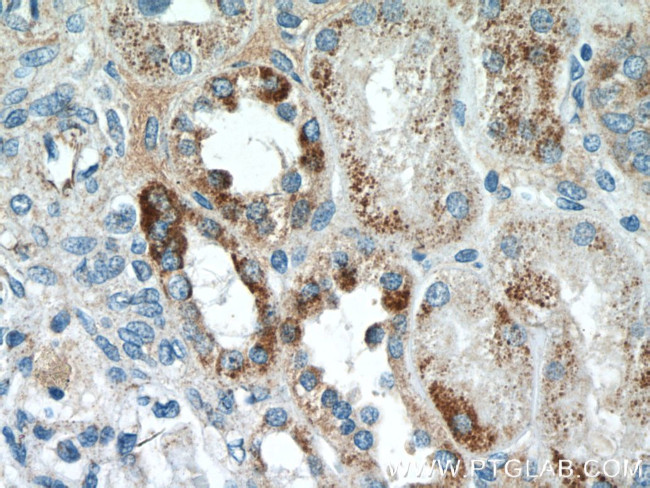
SSU72 Antibody in Immunohistochemistry (Paraffin) (IHC (P))

Search
Proteintech
SSU72 Polyclonal Antibody
{{$productOrderCtrl.translations['antibody.pdp.commerceCard.promotion.promotions']}}
{{$productOrderCtrl.translations['antibody.pdp.commerceCard.promotion.viewpromo']}}
{{$productOrderCtrl.translations['antibody.pdp.commerceCard.promotion.promocode']}}: {{promo.promoCode}} {{promo.promoTitle}} {{promo.promoDescription}}. {{$productOrderCtrl.translations['antibody.pdp.commerceCard.promotion.learnmore']}}
产品信息
15434-1-AP
种属反应
宿主/亚型
分类
类型
抗原
偶联物
形式
浓度
规格
纯化类型
保存液
内含物
保存条件
运输条件
产品详细信息
Immunogen sequence: SNQNRSMEA HNILSKRGFS VRSFGTGTHV KLPGPAPDKP NVYDFKTTYD QMYNDLLRKD KELYTQNGIL HMLDRNKRIK PRPERFQNCK DLFDLILTCE ERVYDQVVED LNSREQETCQ PVHVVNVDIQ DNHEEATLGA FLICELCQCI QHTEDMENEI DELLQEFEEK SGRTFLHTVC FY (14-194 aa encoded by BC008070)
靶标信息
SSU72 is a highly conserved homologue of yeast Ssu72, a CTD phosphatase and a component of the polyadenylation/ termination machinery. The human Ssu72 is located on Chromosome 1p36 and seems to represent a single gene. It was identified as a pRb binding factor and was also shown to interact with TFIIB and yeast PTA1. The ABs recognize a single band of approximately 30 Kda on immunoblots of various human cell lines but do not work well on mouse tissues.
仅用于科研。不用于诊断过程。未经明确授权不得转售。
篇参考文献 (0)
生物信息学
蛋白别名: CTD phosphatase SSU72; FLJ13048; NB4 apoptosis/differentiation related protein; RNA polymerase II subunit A C-terminal domain phosphatase SSU72; RP5-832C2.2; unnamed protein product
基因别名: 1190002E22Rik; 1500011L16Rik; 2610101M12Rik; HSPC182; PNAS-120; RGD1307854; SSU72
UniProt ID: (Human) Q9NP77, (Rat) Q4KLK9, (Mouse) Q9CY97
Entrez Gene ID: (Human) 29101, (Rat) 298681, (Mouse) 68991